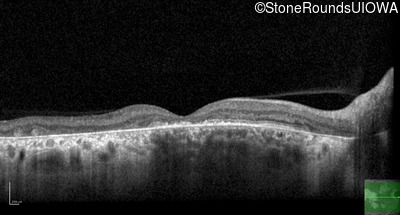
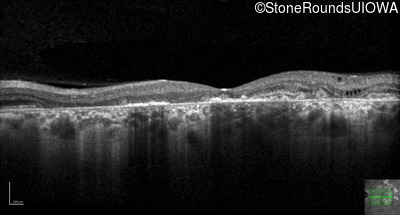

Case
SR3052
Student Mode
AR Stargardt Disease (IIA)
Male
Male
Hidden
SR3052
Student Mode
AR Stargardt Disease (IIA)
Male
Male
History
This 56 year old man underwent surgery for strabismus in early childhood. He felt that his vision was good for most of his life, but about 5 years ago he first experienced difficulty following a golf ball in flight.
Diagnosis & molecular findings
| Disease | Gene | Allele 1 variant(s) | Allele 2 variant(s) | Inheritance mode |
|---|---|---|---|---|
| AR Stargardt Disease | ABCA4 | Asn965Ser AAT>AGT | Glu2131Lys GAA>AAA | AR |
Disease:
Gene:
Allele 1:
Asn965Ser AAT>AGT
Allele 2:
Glu2131Lys GAA>AAA
Inheritance:
AR